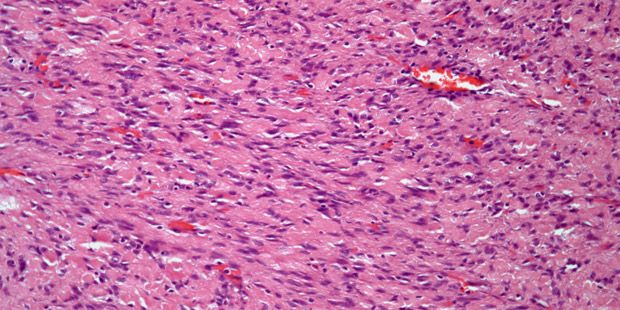

A 46-year-old man presents with abdominal pain. Imaging detects a mass at the level of the ileum, and a biopsy is performed. What is your diagnosis?
A 46-year-old man presents with abdominal pain. Imaging detects a mass at the level of the ileum, and a biopsy is performed.
Based on the image shown, what is your diagnosis?